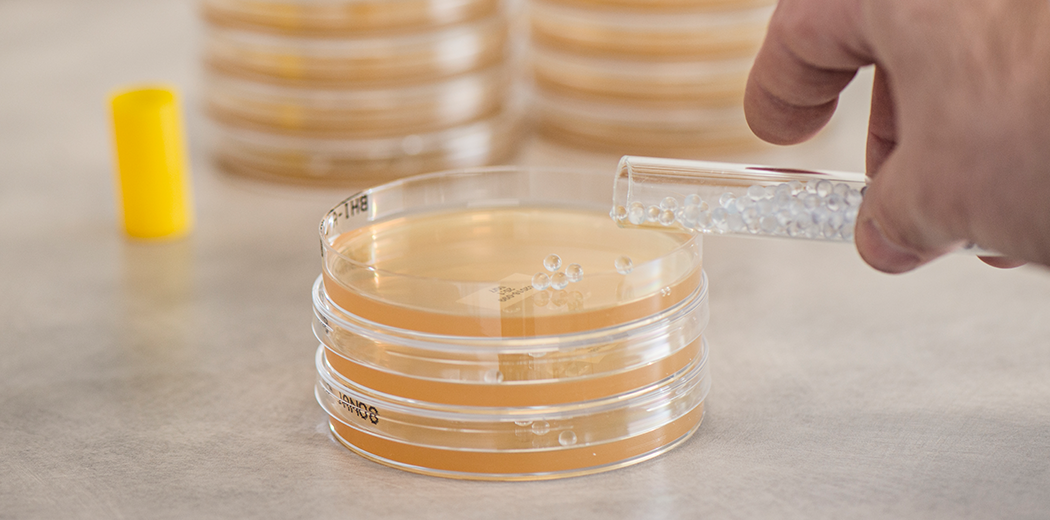
프리바이오틱스란?

프로바이오틱스란?
프로바이오틱스는 유산균을 증식하고 유해균을 억제하며 배변활동을 원활하게 하는데 도움을 주는 건강기능식품의 기능성 원료 입니다.
*출처 : 건강기능식품 기능성원료 2011
프로바이오틱스는 섭취되어 장에 도달하였을 때에 장내 환경에 유익한 작용을 하는 균주를 말합니다. 장에 도달하여 장 점막에서 생육할 수 있게 된 프로바이오틱스는 젖산을 생성하여 장내 환경을 산성으로 만듭니다. 산성 환경에서 견디지 못하는 유해균들은 그 수가 감소하게 되고 산성에서 생육이 잘되는 유익균들은 더욱 증식하게 되어 장내 환경을 건강하게 만들어 줍니다.
* 참고 문헌 : Ouwehand A et al., Probiotics : an overivew of beneficial effects. 82(1-4) : 279-289, 2022년.
프로바이오틱스의 중요성

프로바이오틱스, 왜 먹어야 할까요?
면역 세포의 80%는 장에 존재하며 균형 잡힌 미생물 군과 충분한 양의 좋은 박테리아는 면역 체계가 제대로 기능하는데 가장 중요한 역할을 합니다.
좋은 박테리아는 면역 체계를 교육하여 나쁜 박테리아 및 독소와 같은 원치 않는 침입자와 싸울 준비를 하게 됩니다.
건강한 균형을 이루려면 좋은 박테리아의 수가 나쁜 박테리아보다 10배 (10:1)가량 많아야하며 면역이 깨져 나쁜 박테리아 비율이 증가하게 되면 유산균의 밸런스가 깨지면서 구토, 설사, 변비, 가스, 배앓이, 발열 등의 증상을 나타내기도 합니다.
또한 비만이나 당뇨와 같은 질병의 원인이 되기도합니다.

외부환경 및 스트레스로 인해 신체 바이오리듬과 밸런스가 깨져 면역력이 감소한 사람들에게 추천합니다.
-
· 장시간 의자에 앉아 생활하는 직장인 & 학생
· 다이어트로 인해 화장실 가는게 힘드신 분
· 스트레스로 인해 장이 예민하신 분
· 자주 배가 더부룩하거나 배변 활동이 원활하지 않으신 분
· 활동량이 적은 임산부
· 육류, 인스턴트 섭취가 잦은 분
프로바이오틱스 어떻게 골라야 할까요?

균주
-
· 균주까지 명확하게 입증된 제품인지
· 균주에 대한 특허를 보유하고 있는지
· 유산균이 필요한 신체 부위에 적합한 균주인지
· 효능 효과가 과학적으로 입증 되었는지
· 인체 안정성이 입증 되었는지

함량 및 생존력
-
· 보장균 수 보다 중요한
살아서 장까지 도달하는 유산균의 수
· 섭취자의 연령대를 고려한 보장 균수가 함유되어 있는지

안정성
-
· 제품의 연령대별 안정성 테스트가 완료되었는지
· 위장, 대장, 소장에 부작용 없이 잘 정착하는지

기능성
-
· 소비자가 오인하지 않는 임상자료를 지닌 원료를 사용중인지

제조사 및 원산지
-
· 프로바이오틱 전문 브랜드인지
· 원산지 및 유통 경로가 확인 된 제품인지









